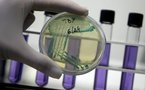
Cancer de la prostate: confirmation de l'inutilité des tests systématiques

|
2496 Résultats pour votre recherche : profit-(h87.cc)-profit->>h87.cc
Aide française post-inondations à Fidji : opération de reconnaissance aérienneAFP | 08/02/2012 | Actualité du Pacifique
La CPS répond au Président du syndicat des médecins libéraux de Polynésie françaisecommuniqué de la CPS | 07/02/2012 | Actualité de Tahiti et ses îles
Pierre Frébault réagit aux propos de Nicolas Sarkozy à propos des chantiers de développement local (CDL)communiqué du MEF | 07/02/2012 | Actualité de Tahiti et ses îles
Extractions à Tubuai: James Salmon réagit à l'article de la dépêcheJames Salmon | 05/02/2012 | Actualité de Tahiti et ses îles
« Sous les prothèses des victimes, il y a un cœur, une vie… »J P TAHITI INFOS REPORTER | 04/02/2012 | Actualité de Tahiti et ses îles
Punaauia: remise d'attestation à la formation "Atelier cuisine"communiqué de la Ville de Punaauia | 29/01/2012 | Actualité de Tahiti et ses îles
La fin du dépistage du cancer du sein en Polynésie française provoque des réactionscommuniqué du TAATIRA NO TE HAU | 26/01/2012 | Actualité de Tahiti et ses îles
CIOM: L'Etat et le Pays partenaires pour le développement endogène.() | 20/01/2012 | Actualité de Tahiti et ses îles
Le ministre de l’Education sur les lieux de l’incendie de Takaroacommuniqué du MEJ | 19/01/2012 | Actualité de Tahiti et ses îles
La plateforme de téléchargement Mega Upload a été mise hors service par le parquet fédéral des Etats UnisAvec AFP | 19/01/2012 | Technologies
GTS propose une "contribution" de l’industrie nucléaire au développement de la PF| 13/01/2012 | Actualité de Tahiti et ses îles
Evasan aux Marquises, et 2ème mission de sauvetage en 15 jours pour les forces arméesFK avec communiqué | 12/01/2012 | Actualité de Tahiti et ses îles
Le GIE Tahiti Tourisme désormais partenaire de l’Association des Hôtels de famille de Tahiti et ses IlesFK avec communiqué | 05/01/2012 | Actualité de Tahiti et ses îles
Exposition collective au golf de Papara : "Le 19ème trou"| 29/12/2011 | Actualité de Tahiti et ses îles
Le Tahoeraa va organiser des Primaires pour désigner ses candidats aux législatives| 21/12/2011 | Actualité de Tahiti et ses îles
|
|
|||
|
TAHITI-INFOS est un site édité par FENUACOMMUNICATION Sarl au capital de 20 000 000 Fcfp, immeuble Manarava - Shell RDO Faa'a - BP 40160 98 713 Papeete Polynésie Française.
(+689) 40 43 49 49 - Dir. de publication : Sarah MOUX - Gérant : Albert MOUX |
||||